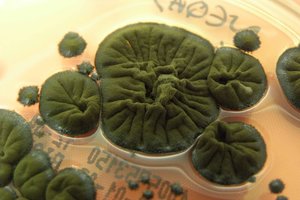
Černobylyje augantis grybas įgavo nepaprastų savybių

Ankstesni tyrimai nebuvo vienareikšmiški dėl to, ar šis genetinis pažeidimas gali būti perduodamas iš tėvų vaikams – tačiau šįkart mokslininkai, vadovaujami Vokietijos Bonos universiteto komandos, ieškojo šiek tiek kitokio atsakymo.
Užuot ieškoję naujų DNR mutacijų kitoje kartoje, jie ieškojo vadinamųjų klasterinių de novo mutacijų (cDNM): dviejų ar daugiau mutacijų, esančių arti viena kitos, rastų vaikuose, bet ne tėvuose. Tai mutacijos, atsiradusios dėl radiacijos poveikio sukeltų tėvų DNR pažeidimų.
„Mes nustatėme, kad apšvitintų tėvų palikuonių cDNM skaičius žymiai padidėjęs, ir nustatėme galimą ryšį tarp apšvitinimo dozės ir cDNM skaičiaus atitinkamuose palikuoniuose, – rašoma moksliniame straipsnyje. – Nepaisant neaiškumo dėl tikslaus jonizuojančios spinduliuotės pobūdžio ir kiekio, šis tyrimas yra pirmasis, pateikiantis įrodymų apie ilgalaikio tėvų apšvitinimo mažomis jonizuojančios spinduliuotės dozėmis transgeneracijos poveikį žmogaus genomui.“
Tikrosios Černobylio katastrofos priežastys ir pasekmės: ekspertai atskleidė detales
Rezultatai pagrįsti visų genomų sekvenavimo tyrimais, atliktais 130 Černobylio katastrofos pasekmes likvidavusių darbininkų palikuonių, 110 Vokietijos karinių radarų operatorių, kurie greičiausiai buvo veikiami šalutinės spinduliuotės, ir 1275 palikuonių, kurių tėvai nebuvo veikiami radiacijos, bet kurie buvo naudojami kaip kontrolinė grupė.
Vidutiniškai mokslininkai nustatė 2,65 cDNM vienam vaikui Černobylio grupėje, 1,48 vienam vaikui Vokietijos radarų grupėje ir 0,88 vienam vaikui kontrolinėje grupėje. Mokslininkai teigia, kad šie skaičiai greičiausiai yra pernelyg dideli dėl duomenų triukšmo, tačiau net ir atlikus statistinius koregavimus, skirtumas vis tiek buvo reikšmingas.
Be to, didesnė tėvų apšvita dažniausiai reiškė didesnį klasterių skaičių vaikams. Tai atitinka idėją, kad radiacija sukuria molekules, žinomas kaip reaktyviosios deguonies rūšys, kurios gali paveikti DNR grandines – pokyčiai, kurie, jei yra netobulai pataisyti, gali palikti šio tyrimo aprašytus klasterius.
Gera žinia yra ta, kad pavojus sveikatai turėtų būti palyginti nedidelis: nebuvo nustatyta, kad apšvitintų tėvų vaikai būtų labiau linkę sirgti ligomis. Tai iš dalies lemia tai, kad daugelis cDNM greičiausiai patenka į „nekoduojančią“ DNR – o ne į genus, kurie tiesiogiai koduoja baltymus.
Susiję straipsniai
„Atsižvelgiant į nedidelį bendrą cDNM padidėjimą po tėvo apšvitos jonizuojančiąja spinduliuote ir nedidelę baltymus koduojančią genomo dalį, tikimybė, kad apšvitintų tėvų palikuonims susirgimus ligomis gali sukelti cDNM, yra minimali“, rašo mokslininkai.
Mokslui žinoma kad vyresnio amžiaus tėvai yra labiau linkę perduoti daugiau DNR mutacijų savo vaikams. Mokslininkai nurodo, kad tokios rizikos, susijusios su tėvų amžiumi pastojimo metu, yra didesnės nei čia nagrinėjama potenciali rizika dėl radiacijos poveikio.
Tačiau reikia atkreipti dėmesį į keletą apribojimų. Kadangi pirminė apšvita įvyko prieš kelis dešimtmečius, tyrėjai turėjo įvertinti ją remdamiesi istoriniais įrašais ir dešimtmečių senumo prietaisais.
Dalyvavimas tyrime taip pat buvo savanoriškas – o tai galėjo turėti tam tikrą įtaką, nes tie, kurie įtarė, kad buvo paveikti radiacijos, galėjo būti labiau linkę dalyvauti tyrime.
Tačiau net ir su šiais apribojimais dabar žinome, kad ilgalaikis poveikis jonizuojančia spinduliuote gali palikti nežymius pėdsakus ateities kartų DNR – tai pabrėžia būtinybę imtis saugos priemonių ir atidžiai stebėti rizikos grupės žmones.
„Galimybė, kad radiacijos sukeltos genetinės mutacijos bus perduotos kitai kartai, kelia ypatingą susirūpinimą tėvams, kurie galėjo būti veikiami didesnėmis jonizuojančios spinduliuotės dozėmis ir galbūt ilgesnį laiką, nei laikoma saugiu“, – rašo mokslininkai.
Tyrimas paskelbtas žurnale „Scientific Reports“.
Parengta pagal „Science Alert“.